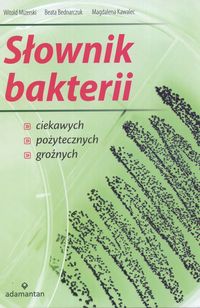

Słownik bakterii:
ciekawych, pożytecznych, groźnych
| Autorzy: | Witold Mizerski Beata Bednarczuk Magdalena Kawalec |
|---|---|
| Wydawca: | Grupa Wydawnicza Adamantan (2004-2008) |
| ISBN: | 978-83-7350-076-1, 83-7350-076-1 978-83-7350-074-1 |
| Autotagi: | druk książki literatura stosowana |
| Więcej informacji... | |
|
|
|
Wypożycz w bibliotece
Kup
Recenzje
Opis
| Inne tytuły: | ciekawych, pożytecznych, groźnych |
|---|---|
| Autorzy: | Witold Mizerski Beata Bednarczuk Magdalena Kawalec |
| oraz: | Beata Bednarczuk |
| Wydawca: | Grupa Wydawnicza Adamantan (2004-2008) |
| ISBN: | 978-83-7350-076-1 83-7350-076-1 978-83-7350-074-1 |
| Autotagi: | druk książki literatura literatura stosowana słowniki |
Powyżej zostały przedstawione dane zebrane automatycznie z treści
10 rekordów bibliograficznych,
pochodzących
z bibliotek lub od wydawców. Nie należy ich traktować jako opisu jednego konkretnego wydania lub przedmiotu.
z bibliotek lub od wydawców. Nie należy ich traktować jako opisu jednego konkretnego wydania lub przedmiotu.